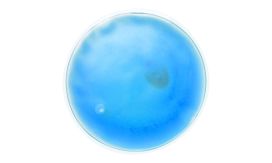

Gestionăm în mod prietenos prezența ta pe website-ul PROMER®! Datele privind navigarea ta pe website sunt adunate sub formă de cookies. Aceste informații sunt folosite strict pentru a-ți oferi o experiență personalizată cât mai apropiată de nevoile tale. Navigând mai departe, îți oferi acordul privind gestionarea datelor de către PROMER®!
Setează preferințele
-
Cookie-uri esentiale / necesare
*esențiale pentru funcționarea platformei, nu pot fi dezactivate -
Cookie-uri de marketing și publicitate
Citește mai multe despre datele de tip Cookie-uri și cum le gestionăm.